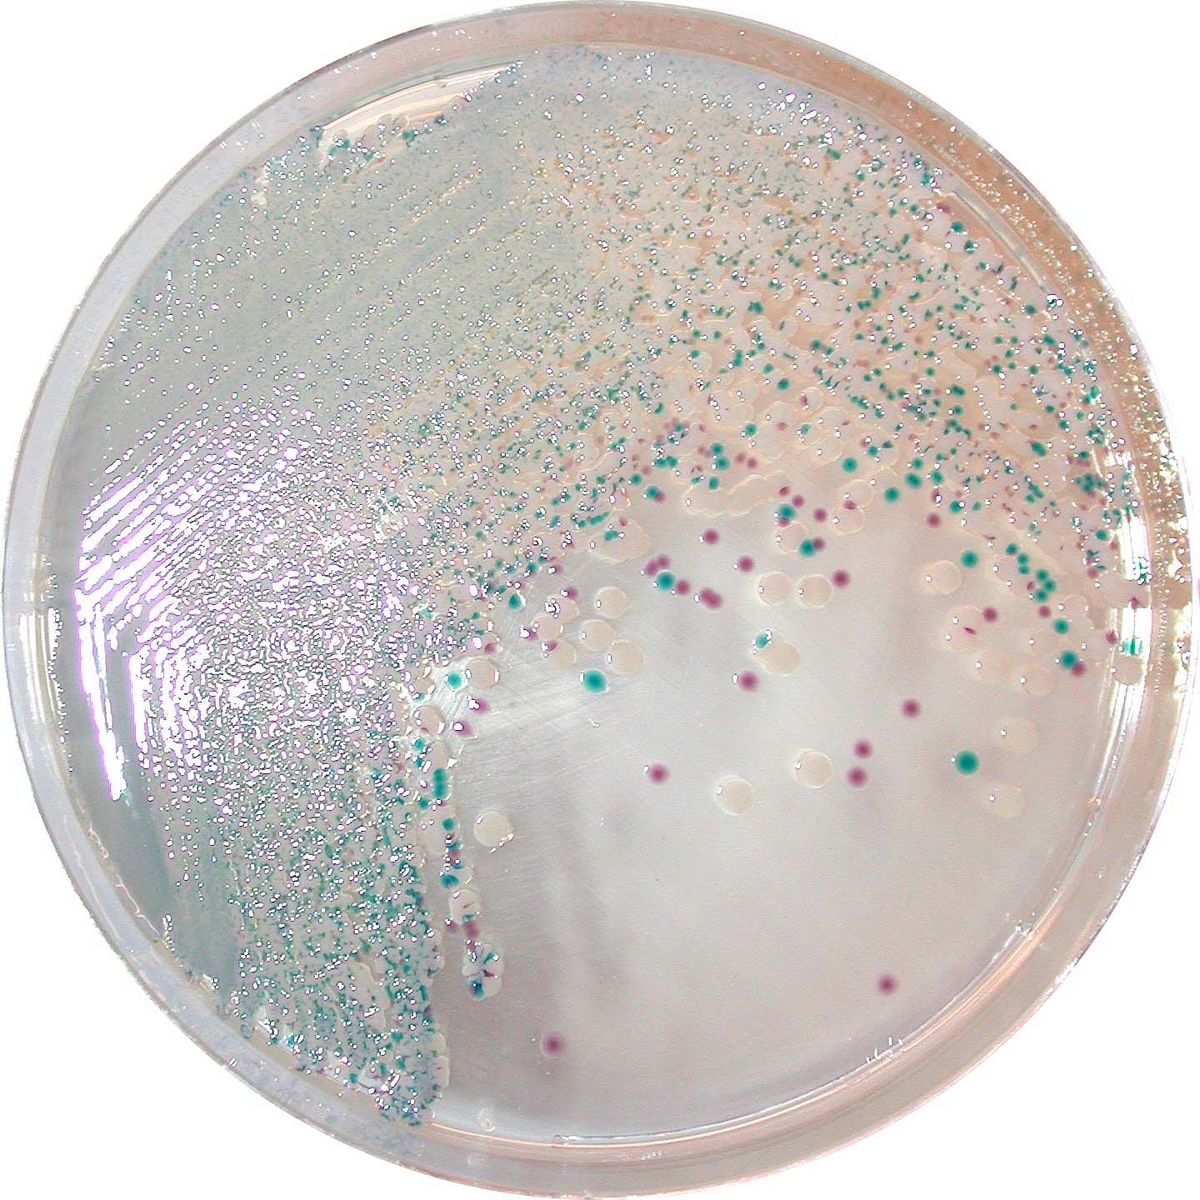

VB913-25
For isolation and detection of V. parahaemolyticus, V. vulnificus and V. cholerae
Package size: 25 L
DKK 8.250,00
DKK 1.875,00
In stock, delivery 1-2 days
Chromogenic medium for isolation and detection of V. parahaemolyticus, V. vulnificus and V. cholerae.
The product is composed of a single powder base.
MEDIUM PERFORMANCE:
1. 3 different clear and intense colony colourations thanks to its powerful chromogenic technology. Easy reading especially when compared to the conventional TCBS medium based on sucrose fermentation revealed with a pH indicator.
2. V. alginolyticus remains colourless in CHROMagar™ Vibrio, avoiding any interference with the detection of other species.
3. Clear differentiation between V. parahaemolyticus and V. vulnificus, both sucrose (-) on TCBS.
4. Unrivalled medium in the chromogenic media field.
5. Recovery of Vibrio is greater than with TCBS agar, even if using an enrichment broth.
6. Fewer false negatives than with TCBS agar.
TYPICAL APPEARANCE OF MICROORGANISMS:
V. parahaemolyticus → mauve
V. vulnificus/V. cholerae → green blue to turquoise blue
V. alginolyticus → colourless
Naturally present on marine plants and animals, Vibrio genus counts over 20 species among which four (V. parahaemolyticus, V. vulnificus, V. alginolyticus and V. cholerae) represent a serious public health hazard.
Also available in 25 L (VB913-25).